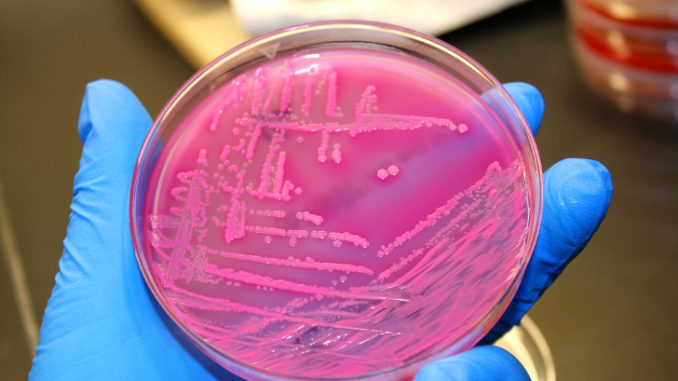

![]()
Contaminazioni da Escherichia Coli: in Francia indagine sulla morte sospetta di un bambino, probabilmente correlata ai lotti di formaggio Reblochon ritirati dal mercato
Le autorità sanitarie francesi stanno indagando sulla morte sospetta di un bambino per scoprire se è stata causata dal consumo di formaggio reblochon, sospettato di essere contaminato da Escherichia coli, e di cui alcuni lotti sono stati ritirati dalla vendita in diversi paesi europei, tra cui l’Italia. “Le indagini su questo caso sono in corso”, ha detto venerdì sera l’Agenzia per la sanità pubblica transalpina, sottolineando che in questa fase non possiamo “né respingere né asserire” che il decesso sia legato al consumo di formaggio reblochon sospettato di essere contaminato da batteri di Escherichia coli. In prima serata, la fabbrica di formaggi della famiglia Chabert, che produce questo reblochon, ha annunciato il ritiro di nuovi lotti “a titolo precauzionale”, dopo due precedenti solleciti dell’11 e del 14 maggio. Diversi lotti sono stati rimossi anche dalle vendite a metà maggio in Germania, Italia, Spagna e Svizzera. Al 31 maggio, quattordici bambini di età compresa da uno a cinque anni furono “inclusi nelle indagini di questa epidemia”, ha detto l’agenzia della sanità pubblica francese. Di questi, sei sono stati infettati con lo stesso ceppo di batteri, ed è noto con certezza che hanno consumato il formaggio reblochon incriminato. Questi sei bambini, che vivono in diverse regioni francesi, sono stati tutti colpiti dalla sindrome emolitica uremica (HUS). Questa malattia, la cui origine è il più delle volte connessa con il cibo, è potenzialmente grave per i bambini: questa patologia è una complicazione di episodi frequenti di diarrea con sangue, che possono causare insufficienza renale acuta. Per gli altri otto bambini “sono in corso le indagini” perché non sappiamo se hanno consumato o meno il reblochon incriminato. “Due di loro hanno mostrato segni di gastroenterite e sei di HUS. Uno dei bambini con HUS è morto”, secondo l’ente pubblico francese che si occupa di sanità, anche se non ha specifica la data di morte o l’età del bambino. Prodotti a Cruseilles, nelle Alpi francesi, i formaggi reblochon sono particolarmente venduti sotto i marchi Chabert, LeTartiflard, nonchè marchi al dettaglio di una serie di catene dell’alimentare tra cui “Le nostre regioni hanno talento” (Leclerc) e dei “Sapori delle nostre regioni” (Lidl ). Un’allerta che lo “Sportello dei Diritti”, aveva già segnalato nelle scorse settimane e che è stata confermata dalle notizie giunte oltralpe in questi giorni. Per Giovanni D’Agata, presidente dell’associazione è opportuno, quindi, continuare a far attenzione a non consumare i lotti di formaggio in questione anche se è altamente probabile che gli stessi non siano più sugli scaffali dei supermercati da tempo.
